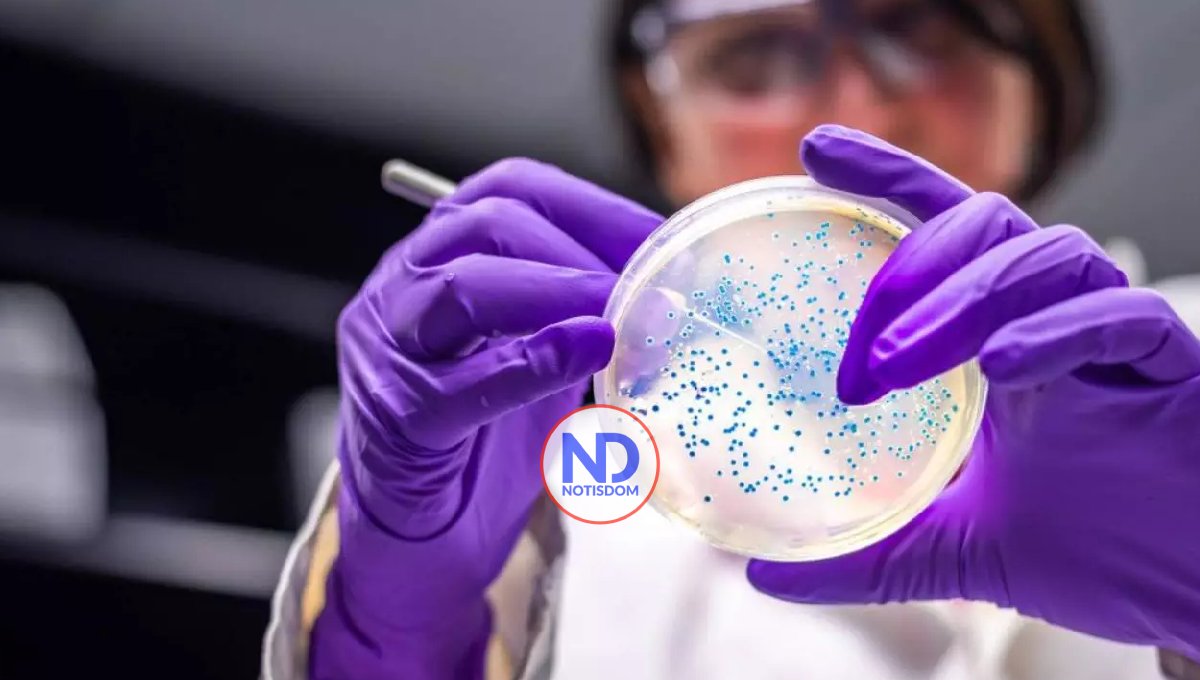
OPS emite alerta epidemiológica por virus de Oropouche

OPS emite alerta epidemiológica por virus de Oropouche
El virus OROV se transmite principalmente al ser humano a través de la picadura de un insecto comúnmente conocido como jején, así como por especies del mosquito Culex.
WASHINGTON.- La Organización Panamericana de la Salud (OPS) emitió una alerta epidemiológica en la que informa a los países y territorios de la región de las Américas sobre la identificación de posibles casos de transmisión materno infantil del virus de Oropouche (OROV) que se están investigando en Brasil. La alerta llama a reforzar la vigilancia ante la posible ocurrencia de casos similares en otros países con circulación de OROV y otros arbovirus.
El virus OROV se transmite principalmente al ser humano a través de la picadura de un insecto comúnmente conocido como jején, así como por especies del mosquito Culex. Fue detectado por primera vez en Trinidad y Tobago en 1955 y desde entonces se han documentado brotes esporádicos en varios países de las Américas, incluyendo Brasil, Ecuador, Guyana Francesa, Panamá y Perú. Recientemente, se ha observado un aumento en la detección de casos en la región.
Entre enero y mediados de julio de 2024, se han notificado casi 7.700 casos confirmados de Oropouche en cinco países de las Américas, siendo Brasil el que registra el mayor número (6.976), seguido de Bolivia, Perú, Cuba y Colombia. La identificación de sospechas de transmisión maternoinfantil del virus se produce en el contexto de este aumento de casos notificados.
En un caso reciente, una mujer embarazada residente del estado de Pernambuco presentó síntomas de Oropouche durante la semana 30 de gestación. Tras la confirmación en laboratorio de la infección por OROV, se reportó posteriormente la muerte del feto. Un segundo caso sospechoso fue notificado en el mismo estado brasileño, donde se observaron síntomas similares en una gestante, y resultó en un aborto espontáneo.
“La posible transmisión vertical y consecuencias en el feto aún están en investigación”, sostiene la OPS en la alerta epidemiológica. “Sin embargo, se comparte esta información con los Estados Miembros para dar a conocer la situación y a la vez solicitar que estén atentos ante la posible ocurrencia de eventos similares en sus territorios”, agrega, con el objetivo de entender mejor esta posible vía de transmisión y sus implicaciones.
El 17 de julio, la OPS publicó directrices para asistir a los países en la detección y vigilancia del virus Oropouche ante posibles casos de infección maternoinfantil, malformaciones congénitas o muerte fetal. La Organización está colaborando estrechamente con los países donde se han confirmado casos para compartir conocimientos y experiencias.
Los síntomas de la enfermedad incluyen la aparición repentina de fiebre, cefalea, rigidez articular, dolores y, en algunos casos, fotofobia, náuseas y vómitos persistentes que pueden durar de cinco a siete días. Aunque la presentación clínica grave es rara, puede evolucionar a meningitis aséptica. La recuperación completa puede llevar varias semanas.
Para controlar el OROV, la OPS llama a los países de la región a implementar medidas de prevención y control de vectores, entre ellas, fortalecer la vigilancia entomológica, reducir las poblaciones de mosquitos y otros insectos transmisores y educar a la población sobre medidas de protección personal, especialmente a las embarazadas, para prevenir picaduras.
Entre las medidas recomendadas se encuentran: proteger las viviendas con mosquiteros de malla fina en puertas y ventanas, usar ropa que cubra piernas y brazos, especialmente en hogares donde haya personas enfermas; aplicar repelentes que contengan DEET, IR3535 o icaridina, y utilizar mosquiteros en camas o muebles donde descansen las personas.
Desde el incremento en el número de casos en la región, la OPS ha brindado apoyo técnico a los países afectados para reforzar su capacidad de detección y confirmación del virus Oropouche. Este esfuerzo incluye la distribución de reactivos para la detección molecular simultánea y de un protocolo que actualmente está disponible en 23 países para facilitar la detección temprana del virus.
Además, la OPS ha organizado diversas actividades como un taller internacional sobre la vigilancia molecular de arbovirus emergentes y reemergentes que reunió a expertos en salud e investigadores de Bolivia, Ecuador, Guyana, Paraguay, Perú, Surinam, Venezuela y Brasil.
Enlaces:
Alerta Epidemiológica Oropouche en la Región de las Américas: evento de transmisión vertical bajo investigación en Brasil – 17 de julio del 2024
Directrices para la Detección y Vigilancia de Oropouche en posibles casos de infección vertical, malformación congénita o muerte fetal
Directrices para la Detección y Vigilancia de Arbovirus Emergentes en el Contexto de la Circulación de Otros Arbovirus
